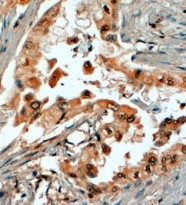

ARG63734
anti-SRD5A1 / 5-alpha reductase 1 antibody
anti-SRD5A1 / 5-alpha reductase 1 antibody for IHC-Formalin-fixed paraffin-embedded sections and Human
Neuroscience antibody; Signaling Transduction antibody
概述
| 产品描述 | Goat Polyclonal antibody recognizes SRD5A1 / 5-alpha reductase 1 |
|---|---|
| 反应物种 | Hu |
| 应用 | IHC-P |
| 宿主 | Goat |
| 克隆 | Polyclonal |
| 同位型 | IgG |
| 靶点名称 | SRD5A1 / 5-alpha reductase 1 |
| 抗原物种 | Human |
| 抗原 | ATATGVAEERLLC |
| 偶联标记 | Un-conjugated |
| 別名 | 3-oxo-5-alpha-steroid 4-dehydrogenase 1; S5AR 1; Steroid 5-alpha-reductase 1; EC 1.3.1.22; SR type 1 |
应用说明
| 应用建议 |
|
||||
|---|---|---|---|---|---|
| 应用说明 | IHC-P: Antigen Retrieval: Steam tissue section in Citrate buffer (pH 6.0). * The dilutions indicate recommended starting dilutions and the optimal dilutions or concentrations should be determined by the scientist. |
属性
| 形式 | Liquid |
|---|---|
| 纯化 | Purified from goat serum by antigen affinity chromatography. |
| 缓冲液 | Tris saline (pH 7.3), 0.02% Sodium azide and 0.5% BSA. |
| 抗菌剂 | 0.02% Sodium azide |
| 稳定剂 | 0.5% BSA |
| 浓度 | 0.5 mg/ml |
| 存放说明 | For continuous use, store undiluted antibody at 2-8°C for up to a week. For long-term storage, aliquot and store at -20°C or below. Storage in frost free freezers is not recommended. Avoid repeated freeze/thaw cycles. Suggest spin the vial prior to opening. The antibody solution should be gently mixed before use. |
| 注意事项 | For laboratory research only, not for drug, diagnostic or other use. |
生物信息
| 数据库连接 |
Swiss-port # P18405 Human 3-oxo-5-alpha-steroid 4-dehydrogenase 1 |
|---|---|
| 基因名称 | SRD5A1 |
| 全名 | steroid-5-alpha-reductase, alpha polypeptide 1 (3-oxo-5 alpha-steroid delta 4-dehydrogenase alpha 1) |
| 背景介绍 | Steroid 5-alpha-reductase (EC 1.3.99.5) catalyzes the conversion of testosterone into the more potent androgen, dihydrotestosterone (DHT). Also see SRD5A2 (MIM 607306).[supplied by OMIM, Mar 2008] |
| 生物功能 | Converts testosterone into 5-alpha-dihydrotestosterone and progesterone or corticosterone into their corresponding 5-alpha-3-oxosteroids. It plays a central role in sexual differentiation and androgen physiology. [UniProt] |
| 研究领域 | Neuroscience antibody; Signaling Transduction antibody |
| 预测分子量 | 29 kDa |
检测图片 (3) Click the Picture to Zoom In
-
ARG63734 anti-SRD5A1 / 5-alpha reductase 1 antibody IHC-P image
Immunohistochemistry: Paraffin-embedded Human prostate tissue. Antigen Retrieval: Steam tissue section in Citrate buffer (pH 6.0). The tissue section was stained with ARG63734 anti-SRD5A1 / 5-alpha reductase 1 antibody at 4 µg/ml dilution followed by HRP-staining.
-
ARG63734 anti-SRD5A1 / 5-alpha reductase 1 antibody IHC-P image
Immunohistochemistry: paraffin embedded Human Prostate. (Steamed antigen retrieval with Tris/EDTA buffer pH 9) stained with ARG63734 anti-SRD5A1 / 5-alpha reductase 1 antibody at 4 µg/ml dilution followed by HRP-staining.
-
ARG63734 anti-SRD5A1 / 5-alpha reductase 1 antibody IHC-P image
Immunohistochemistry: Paraffin-embedded Human liver tissue. Antigen Retrieval: Steam tissue section in Citrate buffer (pH 6.0). The tissue section was stained with ARG63734 anti-SRD5A1 / 5-alpha reductase 1 antibody at 5 µg/ml dilution followed by AP-staining.